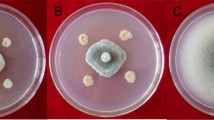

Abstract
Bacillus subtilis CPA-8, a strain with demonstrated ability to control Monilinia spp. in peaches, was studied to elucidate its mechanisms of antifungal activity. Growth inhibition assays using cell-free supernatants and butanolic extracts showed strong antifungal activities against Monilinia laxa and Monilinia fructicola. By comparison with the reference B. subtilis strains UMAF6614 and UMAF6639, fengycin, iturin and surfactin lipopeptides were identified by thin layer chromatography in butanolic extracts from cell-free supernatants, indicating that antibiosis could be a major factor involved in the biological control ability of CPA-8. TLC-bioautography analysis confirmed the presence of fengycin, iturin and surfactin lipopeptides but strong antifungal activity could be associated only with fengycin lipopeptides. These results were definitively supported by mutagenesis analysis targeted to suppress fengycin biosynthesis by disruption of the B. subtilis fenB gene. By TLC-bioautography analysis it was possible to identify transformants from CPA-8 with reduced or suppressed antifungal activity, and this phenotype was associated with the lack of fengycin bands. Fruit trials confirmed that fengycin-defective mutants and their cell-free supernatants lost their ability to control peach brown rot disease in comparison with CPA-8 wild type strain or Serenade Max®, a commercial formulation based on B. subtilis. Furthermore, population dynamics studies determined that CPA-8 fengycin-deficient mutants survived in wounds in peach fruit equally well as the CPA-8 wild type. Taken together our data indicate that fengycin-like lipopeptides play a major role in the biological control potential of B. subtilis CPA-8 against peach brown rot.
Similar content being viewed by others
Avoid common mistakes on your manuscript.
Introduction
Brown rot is of major importance in stone fruit in many countries. Three species of Monilinia are involved in brown rot of stone fruit: M. fructicola (Wint.) Honey, M. fructigena (Aderh. & Ruhl.) Honey, and M. laxa (Aderh. & Rulh.) Honey. In European Mediterranean countries M. laxa is the most important fungal disease of peach (Prunus persica (L.) Batsch (De Cal and Melgarejo 1999). If the weather is wet and cool in the spring, it can reach epidemic levels, and postharvest losses may be high, reaching up to 90%, (Larena et al. 2005). Monilinia fructicola is a quarantined pathogen in Europe (EPPO 2010) which has been recently reported as affecting stone fruit in several countries including Spain (De Cal et al. 2009).
Spray application in the field is the main and often the only method to prevent brown rot during postharvest since chemical fungicides are not authorized to be applied after harvest of stone fruit in the EU (Larena et al. 2005; Mari et al. 2008; Casals et al. 2010d). As a consequence of this, the demand for alternative postharvest disease management practices that could reduce consumer and environmental risks associated with undesirable chemical residues on fruit has increased. In the search for alternatives to chemical control, several strategies including physical methods such as hot water; (Mari et al. 2007) or ultraviolet light (Lu et al. 1991), applications of low toxicity chemicals (Mari et al. 2004; Palou et al. 2009) or natural substances (Mari et al. 2008), curing (Casals et al. 2010a, b), and biological control (Wilson and Pusey 1985; Zhang et al. 2010; Casals et al. 2010c; Yánez-Mendizábal et al. 2011), are being strongly considered.
Among the most promising candidates for biological control agents there are strains of Bacillus subtilis. This bacterium was the first microorganism reported as an effective agent for controlling peach brown rot in postharvest (Pusey and Wilson 1984). The biocontrol potential of B. subtilis strains is based upon their ability to produce a broad array of powerful antibiotic compounds, among which lipopeptides from the fengycin, iturin, and surfactin families can be found (Stein 2005; Ongena et al. 2009).
Lipopeptides of the iturin family, represented by iturin A, mycosubtilin and bacillomycin, are the most commonly studied for their strong antifungal activity against a wide range of plant pathogens (Duitman et al. 1999; Moyne et al. 2004; Arrebola et al. 2010). Surfactins are not fungitoxic by themselves but retain some antifungal activity in synergism with iturin A (Magnet-Dana et al. 1992). Fengycins, which are also called plipastatins, comprise fengycin A and B. Like iturins, they have strong antifungal activity, but act more specifically against filamentous fungi (Vanittanakom et al. 1986). Mechanistically, the action of fengycins is less well known compared with other lipopeptides but they exhibit a good potential to alter structure and permeability of fungal cell membrane (Deleu et al. 2005). Interestingly, fengycins produced by B. subtilis strains have been involved in the control of grey mold on apple, making them interesting molecules with biological control applications on fruit diseases (Touré et al. 2004; Ongena et al. 2005).
In a previous work, the B. subtilis strain CPA-8 isolated in our laboratory demonstrated effective control of brown rot caused by M. laxa and M. fructicola on stone fruit (Casals et al. 2010c; Yánez-Mendizábal et al. 2011). The aim of the present study was to elucidate the main mechanisms responsible for the biocontrol performance of B. subtilis CPA-8 against brown rot. The inhibitory effect of CPA-8 cell free supernatants and lipopeptide extracts were evaluated on M. laxa and M. fructicola growth. Then, the lipopeptide compounds responsible for the antifungal activity of CPA-8 supernatants were identified. The role of these compounds in the antagonism of B. subtilis against M. laxa and M. fructicola was finally determined by analysis of lipopeptide-deficient B. subtilis CPA-8 transformants.
Materials and methods
Microorganisms and culture conditions
The fungi, bacterial strains and plasmid used in this study are listed in Table 1. The plant pathogenic isolates M. laxa CPML1 and M. fructicola CPMC1 were routinely grown on potato dextrose agar plates (PDA) supplemented with 1% acetone, at 25°C for 7 d, and periodically transferred to fresh peaches or nectarines to induce artificial infection and conidial production. Infected fruit were maintained at 25°C and 85% RH in the dark for 7 d. For conidial harvest, conidia were loop washed from the infected fruit surface and suspended in 5 ml of sterile distilled water containing Tween-80 (one drop per litre) and required concentrations were adjusted by haemocytometer.
The B. subtilis strain CPA-8 was isolated from nectarine surface and selected for its preliminary efficacy to reduce brown rot caused by M. laxa and M. fructicola (Casals et al. 2010c; Yánez-Mendizábal et al. 2011). The B. subtilis strains UMAF6614 and UMAF6639 which control the cucurbit powdery mildew fungus Podosphaera fusca (Romero et al. 2004) were obtained from the culture collection of the Laboratory of Microbiology and Plant Pathology, Department of Microbiology, University of Malaga (Spain). CPA-8 mutants were obtained using the integrative plasmid pFen2-2 containing a fragment of fenB gene from B. subtilis (Romero et al. 2006). Bacterial strains and transformants were maintained for long-term storage at −80°C using nutrient broth (NB) supplemented with 9% dimethyl sulfoxide (DMSO). Routinely, fresh bacterial cultures were obtained from frozen stocks before each experiment, and grown at 37°C in nutrient agar (NA), NB or in optimal medium for lipopeptide production (MOLP) (Jacques et al. 1994). Chloramphenicol when required was added to the culture media at 5 μg ml−1.
Antifungal activity assay and identification of antifungal compounds
Antifungal activity of cell-free supernatants and lipopeptide extracts from B. subtilis CPA-8 and the reference strains UMAF6639 and UMAF6614 were tested for their ability to inhibit fungal growth of M. laxa and M. fructicola on agar plates using a technique similar to dual culture analysis (Yoshida et al. 2001). B. subtilis strains were grown in 250 ml conical flasks containing 100 ml of MOLP medium at 37°C and 150 rpm for 72 h. Cell-free supernatants were obtained by centrifugation at 2500 g and 4°C for 15 min followed by filtration through 0.2 μm cellulose nitrate filters. Lipopeptides were extracted from cell-free supernatants using n -butanol following methodology described by Romero et al. (2007). Once the butanol layers were completely evaporated, residues were dissolved in sterile distilled water. An agar plug (5 mm diameter) with actively growing fungal mycelium was placed at the center of 9-cm diameter Petri dishes containing PDA supplemented with 1% acetone. Then, 100 μl aliquots of each cell free supernatant or lipopeptide extract suspension were deposited in 5-mm diameter wells made into the PDA plates at a distance of 3 cm from the fungal plug. Plates were incubated at 25°C for 5 to 7 d. Fungal growth inhibition was calculated by measuring the diameter of fungal colony and expressed as the percentage of inhibition of fungal growth related to the growth obtained in control plates.
The presence of antifungal lipopeptides in bacterial culture supernatants of B. subtilis CPA-8 was analyzed by thin layer chromatography (TLC) (Romero et al. 2007; González-Sánchez et al. 2010). For identification of lipopeptides the reference strains UMAF6614 and UMAF6639 (Romero et al. 2007) were used (Table 1). Briefly, bacterial cultures of these three bacteria were grown on MOLP for 3 d at 37°C. Cell-free supernatants were obtained by centrifugation and then extracted with n-butanol as described above. Once the butanol layers were evaporated to dryness, the residues were dissolved in methanol. Fifty microlitres of each methanolic extracts were inoculated and fractionated by TLC using silica gel plates HPTLC 60-F254 (Merck AG) and a mixture of chloroform–methanol–water (65:25:10, v/v/v). Lipopeptides were visualized by spraying distilled water onto the TLC plates and their corresponding retention factor (Rf) values were estimated (Razafindralambo et al. 1993). To identify the compounds responsible for the antifungal activity of B. subtilis CPA-8, a bioautography TLC analysis was carried out against M. laxa and M. fructicola. Developed TLC chromatograms were placed in 245 × 245 mm cell culture dishes and covered with melted PDA-acetone medium inoculated with M. laxa or M. fructicola at 2 × 105 conidia ml−1. After incubation at 25°C for 5 to 7 d plates were inspected for inhibition zones. The Rf values of the inhibition zones were estimated and compared with those obtained for the different lipopeptides.
Construction and characterization of B. subtilis CPA-8 fengycin-deficient transformants
Site-directed mutagenesis was used to suppress the production of fengycin lipopeptides by inserting the disruption vector pFen2-2 (Table 1), an integrative plasmid containing a partial sequence of the B. subtilis fenB gene involved in fengycin biosynthesis (Romero et al. 2006). Transformation of B. subtilis CPA-8 was carried out according to the protoplast electroporation protocol developed by Romero et al. (2006). Transformants were obtained in NA plates supplemented with 5 μg ml−1 chloramphenicol. The lipopeptide-deficient phenotype of transformants first was evaluated by TLC and subsequently by bioautography analysis against M. laxa and M. fructicola, as described above. Molecular analysis of transformants was carried out by PCR and Southern hybridization using the chloramphenicol resistance cassette and a partial sequence of the target fenB gene, to confirm gene disruption and select single-copy transformants (Romero et al. 2007).
Genomic DNA was isolated using the Ultraclean Microbial DNA kit (Mobio Laboratories). For insertion verification, diagnostics primers were designed on the bases of the chloramphenicol resistance cassette and fenB sequences upstream the fragment inserted in the disruption vector. The PCR reactions were set up in a 25 μl volume containing 1 μl of DNA sample, 1.25 U of Taq DNA polymerase (Roche Diagnostics GmbH), 1 μM of each primer, 200 μM of dNTP mixture and 2.5 μl of 10× reaction buffer. The cycling conditions were as follows: 94°C for 2 min, followed by 30 cycles of 94°C for 1 min, 60°C for 1 min and 72°C for 1 min and a final extension of 72°C for 8 min. The PCR products were analyzed by electrophoresis on 1% agarose gels to verify the reactions. Southern hybridizations were carried out by a digoxigenin enzyme linked immunosorbent assay using a DNA labeling and detection kit (Roche) as recommended in the instruction manual.
Biological control trials on fruit
For biological control trials ‘Roig d’Albesa’ and ‘Plácido’ peaches (Prunus persica (L.) Batsch) were used. Peaches were grown in Ribera d’ Ebre, Segrià and Noguera areas of Catalonia following standard cultural practices without using any postharvest treatment. Fruit with no visible injuries and similar size and visual maturity were selected by hand from fruit bins immediately after harvest. Fruit not used at the time of harvest were stored at 0°C until required for experimentation. Bacterial cell suspensions and cell free supernatants were prepared from 24-h old bacterial cultures in MOLP or MOLP supplemented with 5 μg ml−1 chloramphenicol in the case of mutants, as described above. After centrifugation at 9820 × g and 10°C for 10 min, cells were resuspended in sterile potassium phosphate buffer (PB) solution at pH 6.5 and cell suspensions were adjusted to the desired bacterial concentrations at 107 and 106 colony forming units per milliliter (CFU ml−1). Cell-free supernatants were obtained as indicated above and prepared at 10-fold diluted in PB. Serenade Max® (B. subtilis QST-713; AgraQuest Inc., Davis, California, USA) at the commercial dose of 2.5 g l−1 (approximately at 1.8 × 107 CFU ml−1) was used as a control to compare the treatments with a commercial product. Fruit were wounded on the equator with a nail (3 mm wide and 3 mm deep), and 15 μl of M. laxa or M. fructicola conidial suspensions adjusted to 103 conidia ml−1 were inoculated. After air-drying, 15 μl of each treatment was applied in the same wound site, except for untreated peaches that were inoculated with PB. All fruit trials were carried out by using four replicates and five fruit per replicate. Fruit were incubated at 20°C for 5 d and 85% RH, and the number of brown rot infected fruit was recorded and expressed as disease incidence.
Estimation of bacterial populations in wounds
Bacterial populations of B. subtilis strain CPA-8 wild type and their mutants on ‘Roig d’Albesa’ and ‘Plácido’ peaches were evaluated after 0, 1, 3, and 5 d of storage at 20°C and 85% RH. Fruit management and bacterium treatment at 107 CFU ml−1 was carried out as described above. Five plug samples (10 mm diameter, 5 mm deep) with inoculated wounds, per replicate, were removed from five fruit using a sterile cork borer, placed into sterile plastic filter bags (BagPage 80 ml, Interscience BagSystem, St Nom la Brètech, France) and mixed with 10 ml of sterile PB. Each bag was homogenized in a stomacher blender for 2 min at high speed (Bagmixer 100 Minimix, Interscience). Serial 10-fold dilutions of the homogenization mixtures were made and spread onto NA plates or NA supplemented with 5 μg ml−1 chloramphenicol medium for wild and mutant strains, respectively. Colonies were counted after incubation at 37°C for 24 h. Bacterial populations were estimated and expressed in colony forming units per wound (CFU wound−1).
Statistical analysis
Data for disease incidence were analyzed by SAS software (SAS Institute Inc, Cary, NC, USA). One way analysis of variance (ANOVA) was applied and means were separated by Student Newman Keuls test (P < 0.05). Bacterial population on wounded peaches (CFU wound−1) were log10-transformed (log10 CFU wound−1) to improve homogeneity of variances and plotted in figures where standard deviation errors are shown for each sampling date.
Results
Antifungal activity and identification of antifungal compounds
In order to gain insight into the underlying mechanisms responsible for the outstanding biocontrol performance of B. subtilis CPA-8 towards Monilinia brown rot, the first step was to evaluate the inhibitory effect of cell-free filtrates of B. subtilis CPA-8 on growth of M. laxa and M. fructicola. By means of an in vitro assay similar to the dual culture technique, this strain showed a growth inhibition activity of 80–90% for both fungal pathogens (Table 2). Once the antifungal activity of cell-free filtrates of B. subtilis CPA-8 could be demonstrated, the second step was to evaluate potential implication of Bacillus lipopeptides as the putative compounds responsible for the antifungal activity of the supernatants. To address this, the antifungal activity of butanolic extracts of cell free filtrates of B. subtilis CPA-8 was tested in a similar way that cell-free filtrates, resulting in fungal growth of inhibitions around 90% (Table 2), and pointing to lipopeptides as the compounds responsible for the antifungal activity of B. subtilis CPA-8.
In order to determine the profile of lipopeptides produced by B. subtilis CPA-8, TLC analysis of butanolic extracts of supernatants was undertaken using the lipopeptides produced by the B. subtilis strains UMAF6614 (surfactin, bacillomycin D and fengycin) and UMAF6639 (surfactin, iturin A and fengycin) as standards. TLC analysis showed the production by B. subtilis CPA-8 of the three main families of lipopeptides (Fig. 1a). To establish a direct relationship between single lipopeptides and the antifungal activity of B. subtilis CPA-8, TLC bioautographic analyses were carried using M. laxa and M. fructicola as indicator fungi. Representative results of these analyses are shown in Fig. 1b. For both Monilinia species strong growth inhibition zones, completely inhibiting fungal growth and conidial sporulation, were observed for B. subtilis CPA-8, showing Rf values typical for fengycin-like lipopeptides (0.1–0.2). These inhibition zones were clearly different from those obtained for B. subtilis UMAF6614 and UMAF6639 that were associated with the iturin lipopeptides; iturin A (Rf 0.4) and bacillomycin D (Rf 0.3), respectively, and to a lesser extent with fengycin lipopeptides, in this case only active against M. fructicola. Surfactins (Rf 0.7) produced by the three B. subtilis strains did not show antifungal activity against the fungal pathogens tested.
Thin layer chromatography (TLC) and bioautographic analyses of lipopeptide extracts from B. subtilis CPA-8 and their antifungal activity on M. laxa and M. fructicola. a Butanolic extracts (50 μl) from cell free culture supernatants of B. subtilis CPA-8 and reference strains UMAF6614 and UMAF6639 were fractionated by TLC as described in Materials and methods. b TLC-bioautographyc analyses against M. laxa and M. fructicola, respectively. Developed chromatograms were covered with PDA-acetone medium inoculated with M. laxa or M. fructicola conidia (2 × 105 conidia ml−1). Pictures were taken after 7 d of incubation. The retention factor (Rf) values of the different lipopeptides (srf) surfactin, (ituA) iturin A, (bacD) bacillomycin D and (fen) fengycin are indicated on the left. Fungal growth inhibition zones produced by fengycin activity from B. subtilis CPA-8 are indicated by arrows
Biological control analysis of fengycin-deficient transformants
To determine the contribution of fengycins in the antagonism of B. subtilis CPA-8 against M. laxa and M. fructicola, site-directed mutagenesis was undertaken. The disruption vector pFen2-2 designed by Romero et al. (2006) was used to block the biosynthesis of fengycins by insertion of the construct at the fenB locus. After transformation, five colonies resistant to chloramphenicol were obtained from B. subtilis CPA-8. TLC-bioautography analysis of lipopeptide butanolic extracts from supernatants of CPA-8 transformants showed that compared to CPA-8 wild type, they had lost completely or partially the ability to inhibit growth and conidial sporulation of M. laxa and M. fructicola and therefore, they showed inability to produce fengycins (data not shown). These results indicated that integration events had taken place, and confirmed the expected fengycin-deficient phenotypes. Molecular analyses of the CPA-8 transformants by PCR and Southern blot hybridizations confirmed the correct insertion of the disruption vector within the fenB gene, and permitted to select two single-copy fengycin-deficient transformants (CPA-8::fenB-1 and CPA-8::fenB-2) for further analysis.
The ability of the transformants CPA-8::fenB-1 and CPA-8::fenB-2 to control brown rot elicited by M. laxa and M. fructicola was analyzed using two different fruit hosts, ‘Roig d’Albesa’ and ‘Plácido’ organic peaches (Fig. 2). In these experiments, the efficacy of the fengycin-deficient transformants was studied using either cell suspensions at two different doses (106 and 107 CFU ml−1), and cell-free supernatants 10-fold diluted in PB, and was compared to that obtained by CPA-8 wild type strain and the commercial formulation Serenade Max®. In all cases, brown rot incidence in fruit treated with CPA-8::fenB-1 and CPA-8::fenB-2 mutants was significantly different from results recorded for the CPA-8 wild type and Serenade Max® treatments. Moreover, in most cases the incidence showed by fengycin-deficient transformants was similar to that obtained in the untreated controls. The only exceptions were all the treatments with the transformants at 107 CFU ml−1 that showed incidence values around 50–80% and at 106 CFU ml−1 but only on ‘Plácido’ organic peaches and against M. laxa with incidence values of 60% (Fig. 2c). Even in these cases, the incidence values were very high compared with CPA-8 wild type and Serenade Max® treatments that showed incidence values lower than 10%. Furthermore, all the treatments with 10-fold dilutions of cell-free supernatants from the fengycin-deficient transformants showed incidence values similar to untreated controls whereas the supernatants of the wild type strain suppressed the disease at levels similar to the treatments with cell suspension. These results confirmed the antifungal activity of fengycin and revealed the contribution of this lipopeptide to the biocontrol potential of B. subtilis CPA-8 towards M. laxa and M. fructicola.
Effect of B. subtilis CPA-8 wild type strain and fengycin-deficient derivative mutants on brown rot disease. Effects on four different host-pathogen relationships are shown: a ‘Roig d’Albesa’ peaches and M. laxa, b ‘Roig d’Albesa’ peaches and M. fructicola, c ‘Plácido’ organic peaches and M. laxa, and d ‘Plácido’ organic peaches and M. fructicola. Fruit were wounded, inoculated with M. laxa or M. fructicola at 2 × 103 conidia ml−1 and treated with CK: PB negative control ( ); Ser: Serenade Max® 2.5 g l−1, approx.1.8 × 107 CFU ml−1 (
); Ser: Serenade Max® 2.5 g l−1, approx.1.8 × 107 CFU ml−1 ( ); and bacterial cell suspensions at 107 (
); and bacterial cell suspensions at 107 ( ) and 106 (
) and 106 ( ) CFU ml−1 in PB and cell free culture supernatants 10 fold diluted in PB (
) CFU ml−1 in PB and cell free culture supernatants 10 fold diluted in PB ( ) of B. subtilis CPA-8 wild type strain and fengycin-deficient derivative mutants CPA-8::fenB-1 and CPA-8::fenB-2. After artificially infection, fruit were incubated at 20°C and 85% RH for 5 d and brown rot incidence values were calculated. Bars with different letters are significantly different (P < 0.05) according to SNK test. Results are the means of four independent replications
) of B. subtilis CPA-8 wild type strain and fengycin-deficient derivative mutants CPA-8::fenB-1 and CPA-8::fenB-2. After artificially infection, fruit were incubated at 20°C and 85% RH for 5 d and brown rot incidence values were calculated. Bars with different letters are significantly different (P < 0.05) according to SNK test. Results are the means of four independent replications
Population dynamics of fengycin-deficient transformants
To determine the colonization characteristics of peach fruit by the fengycin-deficient transformants, population dynamics studies on fruit wounds were carried out. In these experiments, B. subtilis CPA-8 wild type strain and the CPA-8::fenB-1 and CPA-8::fenB-2 mutants were inoculated in wounds of ‘Roig d’Albesa’ and ‘Plácido’ peaches with cell suspensions at 107 CFU ml−1. In all cases, populations levels on ‘Roig d’Albesa’ peaches increased from 5.8 to 6.4–6.6 log10 CFU wound−1, during the first 24 h of storage at 20°C and 85% RH (Fig. 3). Then, the populations gradually decreased to 6.3 and 6.5 log10 CFU wound−1 after 3 d, and remained constant until the end of storage period. In addition, the growth curves of CPA-8::fenB-1 and CPA-8::fenB-2 mutants were very similar to that obtained for CPA-8 wild type strain, indicating that the survival capacity and colonization characteristics on fruit of the fengycin-deficient transformants were not altered. Similar resultants were observed in ‘Plácido’ peaches (data not shown).
Population dynamics of B. subtilis CPA-8 wild type strain and fengycin-deficient derivative mutants on wounds of Roig d’Albesa peaches. Wounded fruit were treated with 15 μl of bacterial cell suspensions adjusted to 107 CFU ml−1 in PB. Fruit were incubated at 20°C and 85% RH. Samples were taken at 0, 1, 3 and 5 d after inoculation and bacterial population levels were estimated by dilution and colony counting. Symbols represent: CPA-8 wild type strain (●), and two fengycin-deficient derivative mutants CPA-8::fenB-1 (▲), CPA-8::fenB-2 (■). Values represent the means ± standard error (SE) of three independent replications of five fruit
Discussion
Strains of B. subtilis have been reported as powerful biological control agents of plant diseases due to their ability to produce a wide variety of antimicrobial compounds, including among others lipopeptide antibiotics (Shoda 2000; Stein 2005; Ongena and Jacques 2008). The majority of the studies have been focused primarily on the biocontrol potential of this bacterium to reduce diseases. However, the mechanisms of action of these strains and especially the effect of lipopeptides on the target pathogens have not been extensively investigated (Janisiewicz and Korsten 2002). In postharvest conditions, only a few studies have reported the role of lipopeptides produced by B. subtilis strains, such as iturin A and fengycins, to reduce peach brown rot and gray mold of apple, respectively (Gueldner et al. 1988; Touré et al. 2004; Ongena et al. 2005). In this context, this is the first study which reports the biological potential of a B. subtilis strain to control peach brown rot based on the production of fengycin-like lipopeptides. Our results are similar to those reported by Liu et al (2011) for B. amyloliquefaciens.
The growth inhibition assay performed in vitro supplied the first evidence about the potential role of lipopeptides present in cell free supernatants since most of the antifungal activity of B. subtilis CPA-8 displayed against M. laxa and M. fructicola could be selectively extracted with n-butanol. These results are in agreement with those reported by McKeen et al. (1986) about inhibitory effect of ethanolic extracts from B. subtilis B-3 against a wide range of plant pathogenic fungi, including M. fructicola. The TLC analysis of B. subtilis CPA-8 butanolic extracts in comparison with B. subtilis UMAF6639 and UMAF6614 extracts used as reference strains for lipopeptide production, initially demonstrated the presence of the three different classes of lipopeptides: fengycins, iturins and surfactins, the first two being well known for their strong antifungal activity against a wide spectrum of plant pathogenic fungi (Razafindralambo et al. 1993; Ongena et al. 2009). Furthermore, when this analysis was combined with the growth inhibition test by TLC-bioautography, the CPA-8 lipopeptide fraction corresponding to fengycin showed the highest antifungal activity, whereas iturin A had a limited inhibitory action and surfactin did not display any trace of inhibition activity against M. laxa and M. fructicola. These results strongly support the relevant role of antibiosis based on fengycin production as the major antifungal factor of B. subtilis CPA-8 against M. laxa and M. fructicola. Therefore, CPA-8 can be added to the limited number of Bacillus strains reported to produce fengycin-like lipopeptides that are potentially bioactive to suppress fungal postharvest pathogens (Touré et al. 2004; Ongena et al. 2005).
To clarify the role of bacterial antibiotics in the control ability of plant diseases of a given biocontrol agent, molecular analysis by mutagenesis has been successfully used (Silo-Suh et al. 1994; Hokeberg et al. 1998; Heungens and Parke 2001). Inactivation of antibiotic production by mutagenesis, disrupting biosynthetic genes, generally results in reduction or loss of antagonistic ability to control the pathogen (Raaijmakers et al. 2002). Based on these premises and the antifungal activity previously demonstrated for B. subtilis CPA-8, our main attention was focused on the disruption of fengycin production. A site-directed mutagenesis strategy to inactivate fenB gene of strain CPA-8 was undertaken. The use of the protoplast electroporation protocol developed by Romero et al. (2006) to transform the recalcitrant strains of B. subtilis UMAF6639 and UMAF6614, allowed us to construct CPA-8 mutants deficient for fengycin production. Furthermore, the possibility to introduce disruption vector pFen2-2 into CPA-8 genome gave clear evidence that this procedure is suitable for successful gene manipulation and molecular genetic analysis of this bacterium. Phenotypic and molecular analyses of CPA-8 putative integrative mutants revealed the expected suppression phenotype and indicated that integration events had taken place. According to Romero et al. (2006), although at relative low frequencies, it was enough to select CPA-8 stable integrants.
TLC-bioautography analysis of butanolic extracts showed for some mutants a reduction or a total suppression of the fengycin inhibition properties against M. laxa and M. fructicola compared with CPA-8 wild type extracts. This fact pointed out the importance of this compound in the antagonistic activity of B. subtilis CPA-8 against both pathogens. Moreover, the results obtained in fruit trials using cells and cell-free supernatants confirmed the expected role of fengycin in the disease suppression ability of CPA-8 wild type strain by demonstration of biocontrol efficacy of treatments from wild type in comparison with the inefficacy of the treatments with the CPA-8 fengycin-deficient transformants. Although the treatments with cells from fengycin-deficient mutants retained certain brown rot reduction abilities, their cell-free supernatants were completely ineffective, indicating that fengycin-like lipopeptides are essential to control the disease. The fact that CPA-8 mutants still retained some antifungal activity against brown rot could be related to the ability to produce iturins and surfactins, and the suggested possible occurrence of a synergistic antifungal effect between both lipopeptides, as proposed by others (Magnet-Dana et al. 1992; Arrebola et al. 2010). On the other hand, the biocontrol effect of CPA-8 mutants could be also related to the ability of this bacterium to develop additional biocontrol mechanisms (Janisiewicz and Korsten 2002).
The population dynamics study demonstrated that CPA-8 fengycin-deficient mutants can survive and colonize fruit after 5 days as well as the wild type strain, which indicates that the lost of efficacy to control brown rot can be only attributed to their inability to produce fengycins. This result reinforced previous evidence reported by Touré et al. (2004) and Ongena et al. (2005) on the protective effect of B. subtilis against apple grey mold. In those studies, significant amounts of fengycins were detected by HPLC in apple tissues highly colonized by bacterial cells. Taken together, our findings allowed us to conclude that fengycin is a major factor involved in the biological control ability of B. subtilis strain CPA-8 against peach brown rot elicited by M. laxa and M. fructicola.
From a pathological point of view, few studies have emphasized that the antimicrobial effect of fengycins does not only rely on its chemical structure. Mechanistically, the antifungal action of fengycins is due to their ability to interact with lipid components of the fungal cytoplasmic membrane as ergosterol, and to alter its structure (packing) and permeability in a dose-dependent way (Deleu et al. 2005). Evidence for this assumption was first reported by Vanittanakom et al. (1986) who demonstrated the morphological alterations caused by fengycin obtained from B. subtilis F-29-3 on a wide range of plant fungal pathogens, including M. fructicola, by formation of a fengycin–ergosterol complex. In this sense, the high susceptibility exhibited by M. laxa and M. fructicola could be explained by the effect of fengycins over the target membranes, leading to inhibition of growth and sporulation in both fungal pathogens.
The use of B. subtilis strains to control postharvest diseases is a good alternative to the restricted use of chemical fungicides allowed in fruit management (Janisiewicz and Korsten 2002). Therefore, development of biological formulations based on B. subtilis strains for postharvest use is expected to expand in the future (Fravel 2005; Droby et al. 2009). In this context, the present work provides experimental evidence about the strong antifungal effect and biological control ability of B. subtilis strain CPA-8 to reduce peach brown rot elicited by Monilinia species, which is mostly based on fengycin antibiotic production. The results obtained are similar or even better than those obtained for Serenade Max®, a commercial formulation based on strain B. subtilis QST-713, which supports the possibility of its use as a biological control agent for postharvest diseases and commercial formulation development. However, lipopeptide production could not be the only factor that needs to be considered in the development of this biological control product, and more research on this strain is needed before it can be incorporated in a biological control program for the disease.
References
Arrebola, E., Jacobs, R., & Korsten, L. (2010). Iturin A is the principal inhibitor in the biocontrol activity of Bacillus amyloliquefaciens PPCB004 against postharvest fungal pathogens. Journal of Applied Microbiology, 108, 386–395.
Casals, C., Teixidó, N., Viñas, I., Cambray, J., & Usall, J. (2010a). Control of Monilinia spp. on stone fruit by curing treatments. Part II: The effect of host and Monilinia spp. variables on curing efficacy. Postharvest Biology and Technology, 56, 26–30.
Casals, C., Teixidó, N., Viñas, I., Llauradó, S., & Usall, J. (2010b). Control of Monilinia spp. on stone fruit by curing treatments. Part I: the effect of temperature, exposure time and relative humidity on curing efficacy. Postharvest Biology and Technology, 56, 19–25.
Casals, C., Teixidó, N., Viñas, I., Silvera, E., Lamarca, N., & Usall, J. (2010c). Combination of hot water, Bacillus subtilis CPA-8 and sodium bicarbonate treatments to control postharvest brown rot on peaches and nectarines. European Journal of Plant Pathology, 128, 51–63.
Casals, C., Viñas, I., Torres, R., Griera, C., & Usall, J. (2010d). Effect of temperature and water activity on in vitro germination of Monilinia spp. Journal of Applied Microbiology, 108, 47–54.
De Cal, A., & Melgarejo, P. (1999). Effects of long-wave UV light on Monilinia growth and identification of species. Plant Disease, 83, 62–65.
De Cal, A., Gell, I., Usall, J., Viñas, I., & Melgarejo, P. (2009). First report of brown rot caused by Monilinia fructicola in peach orchards in Ebro Valley, Spain. Plant Disease, 93, 763.
Deleu, M., Paquot, M., & Nylander, T. (2005). Fengycin interaction with lipid monolayers at the air–aqueous interface—implications for the effect of fengycin on biological membranes. Journal of Colloid and Interface Science, 283, 358–365.
Droby, S., Wisniewski, M., Macarisin, D., & Wilson, C. (2009). Twenty years of postharvest biocontrol research: is it time for a new paradigm? Postharvest Biololgy and Technology, 52, 137–145.
Duitman, E. H., Hamoen, L. W., Rembold, M., Venema, G., Seitz, H., Saenger, W., et al. (1999). The mycosubtilin synthetase of Bacillus subtilis ATCC6633: a multifunctional hybrid between a peptide synthetase, an amino transferase, and a fatty acid synthase. Proceedings of the National Academy of Sciences of the United States of America, 96, 13294–13299.
EPPO A2 List of pests recommended for regulation as quarantine pests (version 2010). Retrieved June 27, 2011 from http://www.eppo.org/QUARANTINE/listA2.htm.
Fravel, D. R. (2005). Commercialization and implementation of biocontrol. Annual Review of Phytopathology, 43, 337–359.
González-Sánchez, M. A., Pérez-Jiménez, R. M., Pliego, C., Ramos, C., De Vicente, A., & Cazorla, F. M. (2010). Biocontrol bacteria selected by a direct plant protection strategy against avocado white root rot show antagonism as a prevalent trait. Journal of Applied Microbiology, 109, 65–78.
Gueldner, R. C., Reilly, C. C., Pusey, P. L., Costello, C. E., Arrendale, R. F., Cox, R. H., et al. (1988). Isolation and identification of iturins as antifungal peptides in biological control of peach brown rot with Bacillus subtilis. Journal of Agricultural and Food Chemistry, 36, 366–370.
Heungens, K., & Parke, J. L. (2001). Postinfection biological control of oomycete pathogens of pea by Burkholderia cepacia AMMDR1. Phytopathology, 91, 383–391.
Hokeberg, M., Wright, S. A. I., Svensson, M., Lundgren, L. N., & Gerhardson, B. (1998). Mutants of Pseudomonas chlororaphis defective in the production of an antifungal metabolite express reduced biocontrol activity (Paper presented at the 7th International Congress of Plant Pathology, Edinburgh).
Jacques, P., Hbid, C., Vanhentreyck, F., Destain, J., Bare, G., Razafindralambo, H., et al. (1994). Quantitative and qualitative study of the production of broad-spectrum antifungal lipopeptides from Bacillus subtilis S499 (Paper presented at 6th European Congress on Biotechnology, Florence).
Janisiewicz, W., & Korsten, L. (2002). Biological control of postharvest diseases of fruit. Annual Review of Phytopathology, 40, 411–441.
Larena, I., Torres, R., De Cal, A., Liñan, M., Melgarejo, P., Domenichini, P., et al. (2005). Biological control of postharvest brown rot (Monilinia spp.) of peaches by field applications of Epicoccum nigrum. Biological Control, 32, 305–310.
Liu, J., Zhou, T., He, D., Li, X. Z., Wu, H., Liu, W., et al. (2011). Functions of lipopeptides bacillomycin D and fengycin in antagonism of Bacillus amyloliquefaciens C06 towards Monilinia fructicola. Journal of Molecular Microbiology and Biotechnology, 20, 43–52.
Lu, J. Y., Stevens, C., Khan, V. A., Kabne, M., & Wilson, C. L. (1991). The effect of ultraviolet irradiation on shelf-life and ripening of peaches and apples. Journal of Food Quality, 14, 299–305.
Magnet-Dana, R., Thimon, L., Peypoux, F., & Ptak, M. (1992). Surfactin/iturin A interactions may explain the synergistic effect of surfactin on the biological properties of iturin A. Biochimie, 74, 1047–1051.
Mari, M., Gregori, R., & Donati, I. (2004). Postharvest control of Monilinia laxa and Rhizopus stolonifer in stone fruit by peracetic acid. Postharvest Biology and Technology, 33, 319–325.
Mari, M., Leoni, O., Bernardi, R., Neri, F., & Palmieri, S. (2008). Control of brown rot on stonefruit by synthetic and glucosinolate-derived isothiocyanates. Postharvest Biology and Technology, 47, 61–67.
Mari, M., Torres, R., Casalini, L., Lamarca, N., Mandrin, J. F., Lichou, J., et al. (2007). Control of post-harvest brown rot on nectarine by Epicoccum nigrum and physico-chemical treatments. Journal of the Science of Food and Agriculture, 87, 1271–1277.
McKeen, C. D., Reilly, C. C., & Pusey, P. L. (1986). Production and partial characterization of antifungal substances antagonistic to Monilinia fructicola from Bacillus subtilis. Phytopathology, 76, 136–139.
Moyne, A. L., Cleveland, T. E., & Tuzun, S. (2004). Molecular characterization and analysis of the operon encoding the antifungal lipopeptide bacillomycin D. FEMS Microbiology Letters, 234, 43–49.
Ongena, M., & Jacques, P. (2008). Bacillus lipopeptides: versatile weapons for plant disease biocontrol. Trends in Microbiology, 16, 115–125.
Ongena, M., Henry, G., & Thonart, P. (2009). The roles of cyclic lipopeptides in the biocontrol activity of Bacillus subtilis. In U. Gisi, L. Chet, M. L. Gullino (Eds.), Recent developments in management of plant diseases, plant pathology in the 21st century. (Paper presented at the 9th International Congress of Plant Pathology, Berlin).
Ongena, M., Jacques, P., Touré, Y., Destain, J., Jabrane, A., & Thonart, P. (2005). Involvement of fengycin-type lipopeptides in the multifaceted biocontrol potential of Bacillus subtilis. Applied Microbiology and Biotechnology, 69, 29–38.
Palou, L., Smilanick, J. L., & Crisosto, C. H. (2009). Evaluation of food additives as alternative or complementary to conventional fungicides for the control of major postharvest diseases of stone fruit. Journal of Food Protection, 72, 1037–1046.
Pusey, P. L., & Wilson, C. L. (1984). Postharvest biological control of stone fruit brown rot by Bacillus subtilis. Plant Disease, 68, 753–756.
Raaijmakers, J. M., Vlami, M., & de Souza, J. T. (2002). Antibiotic production by bacterial biocontrol agents. Antonie van Leeuwenhoek International Journal of General and Molecular Microbiology, 81, 537–547.
Razafindralambo, H., Paquot, M., Hbid, C., Jacques, P., Destain, J., & Thonart, P. (1993). Purification of antifungal lipopeptides by reversed-phase high performance liquid chromatography. Journal of Chromatography, 639, 81–85.
Romero, D., de Vicente, A., Rakotoaly, R. H., Dufour, S. E., Veening, J. W., Arrebola, E., et al. (2007). The iturin and fengycin families of lipopeptides are key factors in antagonism of Bacillus subtilis towards Podosphaera fusca. Molecular Plant–Microbe Interactions, 20, 430–440.
Romero, D., Pérez-García, A., Rivera, M. E., Cazorla, F. M., & de Vicente, A. (2004). Isolation and evaluation of antagonistic bacteria towards the cucurbit powdery mildew fungus Podosphaera fusca. Applied Microbiology and Biotechnology, 64, 263–269.
Romero, D., Pérez-García, A., Veening, J. W., de Vicente, A., & Kuiper, O. P. (2006). Transformation of undomesticated strains of Bacillus subtilis by protoplast electroporation. Journal of Microbiological Methods, 66, 556–559.
Shoda, M. (2000). Bacterial control of plant diseases. Journal of Bioscience and Bioengineering, 89, 515–521.
Silo-Suh, L. A., Lethbridge, B. J., Raffel, S. I., He, H. Y., Clardy, J., & Handelsman, J. (1994). Biological-activities of two fungistatic antibiotics produced by Bacillus cereus UW85. Applied and Environmental Microbiology, 60, 2023–2030.
Stein, T. (2005). Bacillus subtilis antibiotics: structures, syntheses and specific functions. Molecular Microbiology, 56, 845–857.
Touré, Y., Ongena, M., Jacques, P., Guiro, A., & Thonart, P. (2004). Role of lipopeptides produced by Bacillus subtilis GA1 in the reduction of grey mould disease caused by Botrytis cinerea on apple. Journal of Applied Microbiology, 96, 1151–1160.
Vanittanakom, N., Loeffer, W., Koch, U., & Jung, G. (1986). Fengycin—a novel antifungal lipopeptide antibiotic produced by Bacillus subtilis F-29-3. The Journal of Antibiotics, 39, 888–901.
Wilson, C. L., & Pusey, P. L. (1985). Potential for biological control of postharvest plant diseases. Plant Disease, 69, 375–378.
Yánez-Mendizábal, V., Usall, J., Viñas, I., Casals, C., Marín, S., Solsona, C., et al. (2011). Potential of a new strain of Bacillus subtilis CPA-8 to control the major postharvest diseases of fruit. Biocontrol Science and Technology, 21, 409–426.
Yoshida, S., Hiradate, S., Tsukamoto, T., Hatakeda, K., & Shirata, A. (2001). Antimicrobial activity of culture filtrate of Bacillus amyloliquefaciens RC-2 isolated from mulberry leaves. Phytopathology, 91, 181–187.
Zhang, D., Spadaro, D., Garibaldi, A., & Gullino, M. L. (2010). Selection and evaluation of new antagonists for their efficacy against postharvest brown rot of peaches. Postharvest Biology and Technology, 55, 174–181.
Acknowledgements
The authors are grateful to the Spanish Government, Ministerio de Asuntos Exteriores de Cooperación, Agencia Española de Cooperación Internacional para el Desarrollo (AECID) for grant scholarship 0000308852 (V. Yánez-Mendizábal), Plan Nacional de I+D+I of the Ministerio de Ciencia e Innovación (AGL2007-65340-CO2-01), co-financed with FEDER funds (European Union), the REDBIO European Project and the UdL (University of Lleida) Organic Project 2009 for their financial support.
Author information
Authors and Affiliations
Corresponding author
Rights and permissions
About this article
Cite this article
Yánez-Mendizábal, V., Zeriouh, H., Viñas, I. et al. Biological control of peach brown rot (Monilinia spp.) by Bacillus subtilis CPA-8 is based on production of fengycin-like lipopeptides. Eur J Plant Pathol 132, 609–619 (2012). https://doi.org/10.1007/s10658-011-9905-0
Accepted:
Published:
Issue Date:
DOI: https://doi.org/10.1007/s10658-011-9905-0